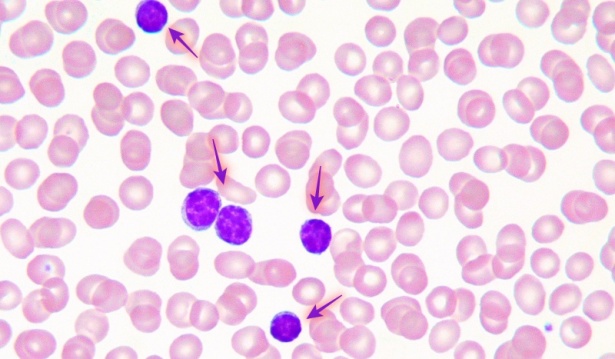
() -

Повишени лимфоцити (лимфоцитоза)
› По-чести причини за възникване
Въведение
Повишени нива на лимфоцити (лимфоцитоза) представлява състояние, при което броят на лимфоцитите е по-висок от референтните стойности. Нормално лимфоцитите формират около 20-40 % от всички левкоцити. Лимфоцитозата (повишен брой лимфоцити) може да бъде временна реактивна промяна или да отразява подлежащо патологично състояние. Тя не е самостоятелен диагноза, а лабораторен знак, който изисква установяване на причината.
Лимфоцитите са тип бели кръвни клетки (левкоцити), които имат ключова роля в имунната защита. Те участват в разпознаването и елиминирането на инфекциозни агенти, в специфичния имунитет, произвеждането на антитела и в клетъчната защита. Абсолютният им брой (ALC, absolute lymphocyte count) при възрастни варира приблизително между 1 000 и 4 500 лимфоцити/µl (или между 1,0 и 4,5 × 10^9/л). При някои лаборатории може да се наблюдават различни референтни граници.
Повишени нива на лимфоцити (лимфоцитоза) може да се дължи на:
- Инфекциозни и паразитни болести - рубеола, паротит, морбили, варицела, токсоплазмоза, жлезиста треска, цитомегаловирусна инфекция, инфекциозна мононуклеоза, хепатит А, сифилис, бруцелоза, вирус на Епщайн-Бар (Epstein-Barr virus), коклюш, туберкулоза.
- Травми, отравяния и други последици от въздействието на външни причини - масивни травматични увреждания, хирургични интервенции, тежки изгаряния.
- Новообразувания - лимфосарком, фоликуларен лимфом, остра лимфобластна левкемия, хронична лимфоцитна левкемия, лимфом на Бъркит, миелом.
- Страничен ефект от прием на медикаменти - фенитоин, етотоин.
Видове лимфоцити

Изображение: Navngivelse 4.0 Internasjonal, CC BY 4.0
Лимфоцитите представляват специализирани клетки на имунната система, които осигуряват специфичен имунен отговор срещу чужди антигени.Те се развиват от стволовите клетки на костния мозък и преминават през процес на диференциация и съзряване в различни лимфоидни органи (тимус, слезка, лимфни възли и лимфоидна тъкан, асоциирана с лигавиците - MALT).
Основната им функция включва разпознаване на специфични антигени и изграждане на имунологична памет. Това осигурява по-бърз и ефективен отговор при повторен контакт със същия причинител. В кръвта и лимфните органи лимфоцитите се разпределят на различни подтипове според произхода и функцията си.
Основните видове лимфоцити са:
В-лимфоцити
Произхождат от костния мозък и отговарят за хуморалния имунитет – тоест за продукцията на антитела. След среща с антиген, В-клетките се активират и се диференцират в плазматични клетки, които синтезират специфични имуноглобулини (IgG, IgM, IgA, IgE). Част от В-лимфоцитите остават като клетки на паметта, които осигуряват бърз имунен отговор при повторна инфекция.
Т-лимфоцити
Образуват се в костния мозък, но узряват в тимуса. Те са отговорни за клетъчния имунитет, т.е. разпознават и унищожават инфектирани или абнормни клетки. Според функцията си Т-лимфоцитите се делят на няколко подгрупи:
- Т-хелпери (CD4+): регулират активността на други имунни клетки чрез освобождаване на цитокини; подпомагат В-лимфоцитите да произвеждат антитела.
- Т-цитотоксични (CD8+): унищожават вирусно инфектирани и туморни клетки чрез освобождаване на специални молекули.
- Т-регулаторни: потискат прекомерни имунни реакции и предотвратяват автоимунитет.
NK-клетки (Natural Killer cells)
Принадлежат към лимфоцитната линия, но са част от вродения имунитет. Те не се нуждаят от предварителна активация от антиген и унищожават клетки, които не експресират нормални „собствени“ маркери.
В нормални условия около 70-80 % от циркулиращите лимфоцити са Т-клетки, 10-20 % - В-клетки и 5-10 % - NK-клетки. Балансът между тези популации е важен за адекватен имунен отговор и имунологична толерантност. Нарушения в съотношението им се наблюдават при инфекции, автоимунни заболявания, имунодефицитни състояния и злокачествени лимфопролиферации.
Видове лимфоцитоза
Лимфоцитозата най-общо се класифицира според механизма на възникване и характера на клетъчното увеличение.
- Първична лимфоцитоза - Характеризира се с персистиращо и често изразено увеличение на лимфоцитите, които произлизат от един абнормен клон клетки. Това състояние е част от групата на лимфопролиферативните заболявания
- Вторична лимфоцитоза (реактивна) - Това е най-честата форма и представлява временна, обратима имунна реакция на организма към инфекция, възпаление, стрес или други стимули.Типични причини са вирусни инфекции, някои бактериални или паразитни заболявания, както и след физически стрес или тежка травма. След овладяване на причината най-често броят на лимфоцитите се нормализира.
- Абсолютна лимфоцитоза - Налице е увеличение на абсолютния брой лимфоцити в периферната кръв над горната референтна граница (обикновено > 4,5 × 109/л при възрастни). След овладяване на причината, броят на лимфоцитите се нормализира.
- Относителна лимфоцитоза - Представлява увеличение на процента лимфоцити сред общия брой левкоцити в периферната кръв, при нормален или нисък общ брой левкоцити. Обикновено се приема, че относителна лимфоцитоза е налице, когато лимфоцитите съставляват над 40% от всички левкоцити при възрастни.
По-чести причини за възникване
Стрес
Физическият и психическият стрес могат временно да повишат нивото на лимфоцитите в кръвта. Това се дължи на освобождаването на хормони като адреналин и кортизол, които предизвикват преразпределение на лимфоцитите от лимфните органи към периферната циркулация. Обикновено това е преходна реакция, която не изисква лечение и отзвучава след отстраняване на стресовия фактор.
Травма
Лимфоцитозата при травма обикновено е краткотрайна и се нормализира след възстановяването на тъканите. Среща се най-често след тежки наранявания, изгаряния или оперативни интервенции. Наблюдава се динамична промяна между неутрофили и лимфоцити, като лимфоцитозата може да е част от стресовия отговор. В повечето случаи не е признак на заболяване, а физиологичен отговор на организма.
Инфекциозни болести
Най-честата причина за лимфоцитоза са вирусните инфекции. При тях лимфоцитите се размножават активно в отговор на вирусните антигени. Сред вирусните заболявания, при които се наблюдава лимфоцитоза, най-често срещани са:
- Инфекциозна мононуклеоза (Epstein-Barr вирус)
- Цитомегаловирусна инфекция
- Рубеола
- Морбили
- Паротит
- Варицела
- Хепатит А
- Коклюш
Бактериални инфекции като туберкулоза и сифилис, както и паразитни заболявания като токсоплазмоза, също могат да причинят лимфоцитоза.
Прием на медикаменти
Някои лекарства могат да индуцират повишаване на лимфоцитите като страничен ефект. Класически пример са антиепилептичните медикаменти фенитоин и етотоин, които могат да доведат до реактивна лимфоцитоза.В редки случаи лекарствената лимфоцитоза може да бъде част от синдром на лекарствена реакция с еозинофилия и системни симптоми (DRESS), което изисква спешна лекарска намеса.
Новообразувания
Неопластичните заболявания на лимфоидната тъкан са сериозна причина за персистираща лимфоцитоза. Най-често това са хронична лимфоцитна левкемия (ХЛЛ), лимфоми и остра лимфобластна левкемия. При тези състояния се наблюдава клонална пролиферация на злокачествено трансформирани лимфоцити, които се натрупват в периферната кръв, костния мозък и лимфните възли. Лимфоцитозата е устойчива, прогресивна и често се съпров
Симптоми

Лимфоцитозата сама по себе си често е асимптомна и се открива при рутинно кръвно изследване. При реактивна лимфоцитоза симптомите се дължат на основното заболяване. Чести прояви включват:
- Повишена температура
- Отпадналост
- Главоболие
- Кашлица
- Носна секреция
- Зачервяване и болки в гърлото
- Лесна уморяемост
Особено внимание трябва да се обърне при персистираща лимфоцитоза, както и при появата на нови симптоми като нощно изпотяване, загуба на тегло, сърцебиене и увеличение на лимфните възли.
Диагноза

Диагностиката на лимфоцитозата има за цел да установи дали увеличеният брой лимфоцити е реактивен (в резултат на инфекция или възпаление) или клонален (поради хематологично заболяване). Процесът започва с рутинно лабораторно изследване и се надгражда с по-специфични тестове според клиничната картина. Основните стъпки включват:
- Пълна кръвна картина (ПКК): лимфоцитите обикновено представляват 20 до 40% от циркулиращите бели кръвни клетки. Абсолютният брой на лимфоцитите (ALC) може да бъде пряко измерен чрез флоуцитометрия или се изчислява като се умножи общия брой на белите кръвни клетки (WBC) от процентното съдържание на лимфоцитите, намерени при диференциално броене.
- Микроскопско изследване на кръвна натривка: позволява оценка на морфологията на лимфоцитите
- Вирусологични и серологични изследвания: включват тестове за EBV, CMV, HIV, HBV и HCV.
- Изследване на костен мозък: извършва се при съмнение за лимфопролиферативно заболяване или левкемия. Изследването се прави чрез пункция -и аспирация на костен мозък, последвана от цитоморфологично и имунофенотипно изследване.
- Имунофенотипизация (флоуцитометрия): Извършва се за установяване на клоналност и определяне дали лимфоцитите са от B-, T- или NK-произход.
- Допълнителни тестове: по преценка на лекаря могат да се назначат други кръвни изследвания, както и цитогенетични и молекулярни анализи.
- Образна диагностика: при данни за лимфаденопатия или органомегалия се препоръчват и образни изследвания (ехография, CT, PET/CT, ЯМР)
Лечение

Лечението на повишени нива на лимфоцитите се определя от подлежащата причина. При реактивна лимфоцитоза терапията е насочена към основното заболяване - вирусните инфекции се лекуват симптоматично, а бактериалните с подходящ антибиотик. При клонална лимфоцитоза, каквато се наблюдава при хронична лимфоцитна левкемия и други лимфопролиферативни синдроми, лечението се провежда от хематолог и включва химиотерапия, имунна терапия, таргетни медикаменти, а при напреднали случаи - трансплантация на костен мозък.
Заглавно изображение: Echinaceapallida, CC BY-SA 4.0, via Wikimedia Commons
Изображения: freepik.com
Заболявания при симптом Повишени лимфоцити (лимфоцитоза)
- Болест на Kaschin-Beck
- Други и неуточнени лекарствени средства и медикаменти
- Други и неуточнени лекарствени средства, медикаменти и биологични вещества
- Други петнисти трески
- Подостра лимфоцитна левкемия
- Хемофагоцитна лимфохистиоцитоза
Библиография
https://www.ncbi.nlm.nih.gov/books/NBK549819/
https://my.clevelandclinic.org/health/diseases/17751-lymphocytosis
https://www.mayoclinic.org/symptoms/lymphocytosis/basics/causes/sym-20050660
https://www.physio-pedia.com/Lymphocytes
https://redcliffelabs.com/myhealth/health/high-lymphocytes-causes-symptoms-and-treatment/
Коментари към Повишени лимфоцити (лимфоцитоза)